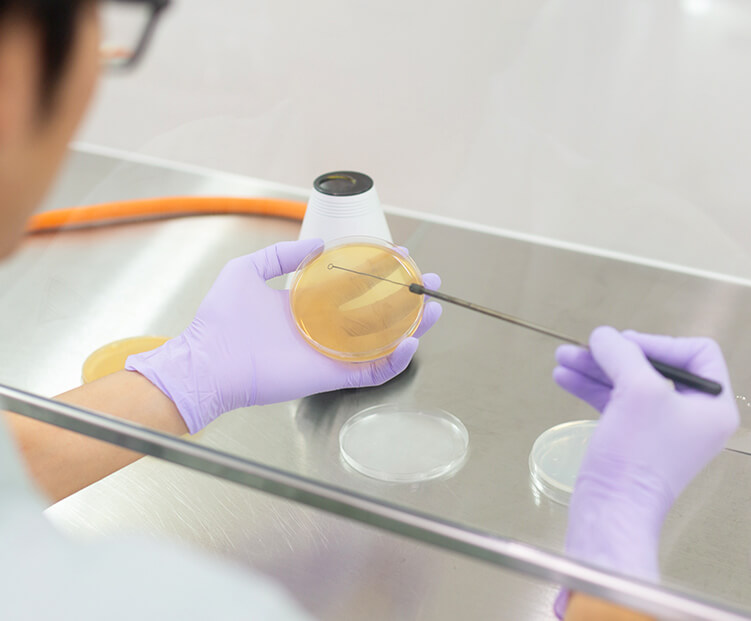

소주 제조의 원료인 고구마에 숨겨진 가치를 연구하여 새로운 주질 개발에 힘쓰고 있습니다.
연구 개요
본격 고구마 소주의 연구 대상은 원료인 고구마와 쌀, 국균을 이용한 누룩 제조, 효모를 통한 발효, 증류, 숙성이라는 다방면에 걸쳐 있으며 모든 요소가 조화를 이루어야 맛있는 소주가 완성됩니다. 기리시마 주조는 100년에 걸쳐 쌓아온 전통에 혁신적인 발상과 기술을 도입하여 새로운 주질을 개발하고, 이를 통해 편안한 시간을 선사할 수 있기를 바랍니다.
또한 소주와 소주 제조 과정에서 생성되는 부산물, 건강을 콘셉트로 한 ‘겐레이슈’의 기능성을 연구하여 건강하고 풍요로운 삶에 기여하고자 합니다.

연구
1


고구마를 이용한 상품 개발
고구마 소주 제조에서 고구마는 쌀의 약 5배 되는 양이 사용되며, 고구마 품종의 차이는 고구마소주의 주질을 크게 좌우합니다. 더 나은 소주를 만들기 위해 고구마 재배 특성을 파악하고 소주의 관능 평가와 향기성분 분석을 하여 소주에 적합한 고구마 품종을 연구하고 있습니다.

고구마 재배 방법과 재배지 환경 연구
원료를 안정적으로 확보하기 위해 고구마 재배 방법과 재배지 환경 측정 등을 관련 부서에서 협력하며 정부 및 지역 연구기관, 대학, 생산 농가와 함께 연구를 수행하고 있습니다.
연구
2

발효와 양조라는 일본의 전통적인 기술에 최첨단 과학을 도입하여 더욱더 맛있는 소주 개발에 힘쓰고 있습니다.

양조 미생물 연구
기호가 다양해지면서 다양한 풍미를 지닌 소주가 요구되고 있습니다. 국균과 효모균에 대해 깊이 연구하고, 나아가 새로운 기술을 응용하여 사회적 니즈에 부합하는 상품 개발에 힘쓰고 있습니다.

제조 기술 개발
국균과 효모균이 활발하게 작용할 수 있도록 누룩 제조와 발효 조건을 검토하여 품질 향상을 목표로 하고 있습니다. 새로운 균주나 원료를 사용할 때는 조건을 세밀하게 설정하여 제품의 특장점을 최대한 끌어낼 수 있도록 힘쓰고 있습니다.
연구
3

고객의 니즈에 맞춰 맛과 기능성을 갖춘 제품 개발에 힘쓰고 있습니다.

기능성 연구
식품의 기능으로 기존에는 영양과 기호성이 요구되었지만, 최근에는 그에 더해 건강 기능성에 대한 요구도 강해졌습니다. 이에 고기능성 소재와 소주를 융합한 ‘겐레이슈’ 개발에 힘쓰고 있습니다.

부산물의 효과적인 이용
소주 제조 과정에서 발생하는 부산물에는 다양한 성분이 포함되어 있습니다. 기존에는 해당 부산물을 열적 재활용(※)하는 방식으로 활용했지만, 식품으로서 효과적으로 이용하기 위해 부산물의 기능성 성분과 생리활성 메커니즘을 규명하여 기능성 소재로 이용하는 방법을 개발하는 데 힘쓰고 있습니다.
- 폐기물을 단순 소각 처리하는 것이 아니라, 소각 과정에서 발생하는 에너지를 회수하여 이용하는 것.

향미에 관여하는 성분의 규명
소주에는 다양한 성분이 함유되어 있지만, 향미에 기여하는 모든 성분은 아직도 규명되지 않았습니다. 따라서 소주의 단맛과 풍미를 조절할 수 있는 양조 기술의 확립을 목표로, 각 원료와 소주에 대한 포괄적인 분석과 관능 평가를 조합하면서 향미 기여 성분을 규명하는 데 힘쓰고 있습니다.



